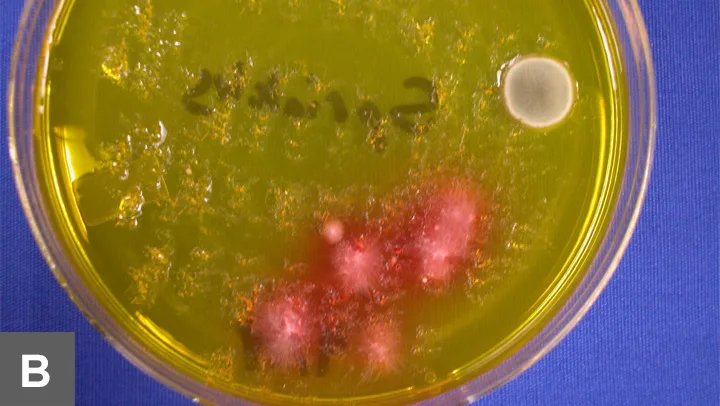
Featured Image

This response is incorrect. See below for the correct answer.
Microscopic Examination of Fungal Cultures
Although there are many pathogenic dermatophytes, the 3 most common pathogens encountered in small animal practice are Microsporum canis__, M gypseum, and Trichophyton.
On occasion, other pathogens may be isolated but this is rare. The use of mediums such as dermatophyte test medium (DTM) is encouraged because it contains a color indicator and antimicrobial agents that inhibit most, but not all, contaminant growth. The number of colonies that need to be sampled and examined microscopically can be limited by focusing on white- to buff-colored colonies producing a red color change in the medium; the red color change must occur simultaneously with the appearance of grossly visible colony growth. Plates should be examined daily-once the entire plate turns red, the value of the color indicator as a "red flag" is gone. Some contaminants will have the right gross appearance and produce the simultaneous red color change, so all suspect colonies should be checked microscopically. M canis, M gypseum, and Trichophyton have rather characteristic microscopic morphologies; however, if help is needed in identification, see www.doctorfungus.org. For future use in identification, pictures of organisms can be photographed directly through the microscope eyepiece using a digital camera. Many of the pictures in this article were taken with this technique.
Fungi versus Contaminants-Plates
Both colonies on these plates (A) can be identified as contaminants by gross examination alone. The white colony (right) is not producing a red color change as it is growing and the colony that is producing a color change (left) is pigmented. Pigmented colonies are contaminants.

White colonies producing a red color change in the medium around them as they grow (B) should be examined microscopically. Note that one colony growing on the plate does not have a red color change surrounding it, which indicates that it is a contaminant.

Figure 1A.
Slides are first examined at 10× to look for hyphae and sporulation. Once a site has been found, the slide is examined at 40× to determine if it shows a possible pathogen. Microscopic colonies can be eliminated as contaminants if the colonies are pigmented (dematiaceous) (A) or if the hyphae are aseptate.
Trichophyton

Trichophyton species are the most difficult of the common pathogens to identify. These colonies are often slow to grow and it is recommended to observe the plate for 21 days, especially if the sample is from a highly suspect patient (eg, small mammal, small animal exposed to farm animals, hedgehogs). Suspect colonies may require subculture if the colony is at risk for being swarmed by overgrowth. Many species require specific incubation temperatures and enriched mediums; however, the more common species (eg, T mentagrophytes and T verrucosum) will grow on DTM.
Key characteristics include the presence of large numbers of spherical micronidia (red arrows), rare macroconidia (arrow), and spiral hyphae (arrowheads) (A and B). Spiral hyphae can be found in other dermatophytes such as M persicolor; this organism can look very similar to T mentagrophytes but a few characteristics help differentiate the two. First, T mentagrophytes_will produce macroconidia without special subculturing. While macroconidia are not present in high numbers, they can be found in most specimens with careful examination; however, _M persicolor often has to have macro-conidia induced via special subculture. In addition, M persicolor does not grow well at 37°C but T mentagrophytes does.

A complete discussion on preparing fungal cultures and slides for microscopic examination (Procedures Pro: Fungal Cultures for Diagnosing Dermatophytes) was published in the October 2007 issue of Clinician's Brief.